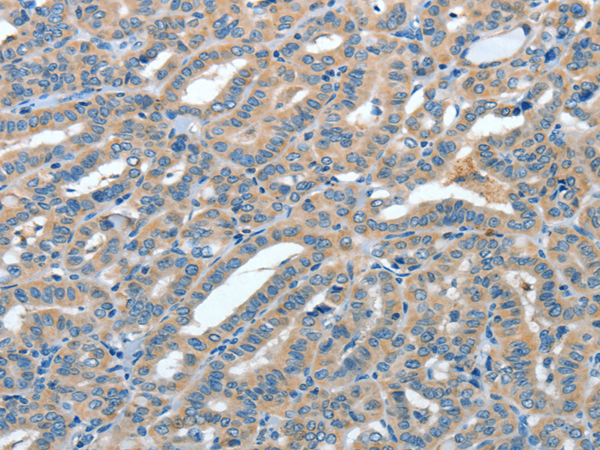

提醒成功

搜索
Rabbit Polyclonal Antibody to ANGPT1
-
货号:
P00152 -
别名:
AGP1; AGPT; ANG1 -
产品上架时间:
2024-01-01 -
应用:
WB,IHC -
反应种属:
Human, Mouse, Rat -
抗体类型:
Primary antibody -
Swissprot:
Q15389 -
规格:
-
数量:
-+ -
说明书:
目录价¥1980

Rabbit Polyclonal Antibody to ANGPT1
Description |
|---|
This gene encodes a secreted glycoprotein that belongs to the angiopoietin family. Members of this family play important roles in vascular development and angiogenesis. All angiopoietins bind with similar affinity to an endothelial cell-specific tyrosine-protein kinase receptor. The protein encoded by this gene is a secreted glycoprotein that activates the receptor by inducing its tyrosine phosphorylation. It plays a critical role in mediating reciprocal interactions between the endothelium and surrounding matrix and mesenchyme and inhibits endothelial permeability. The protein also contributes to blood vessel maturation and stability, and may be involved in early development of the heart. Alternative splicing results in multiple transcript variants encoding distinct isoforms. |
Specification |
|
|---|---|
| Aliases | AGP1; AGPT; ANG1 |
| Swissprot | Q15389 |
| WB Predicted band size | 58 kDa |
| Host/Isotype | Rabbit IgG |
| Antibody Type | Primary antibody |
| Storage | Store at 4°C short term. Aliquot and store at -20°C long term. Avoid freeze/thaw cycles. |
| Species Reactivity | Human, Mouse, Rat |
| Immunogen | Full length fusion protein |
| Formulation | Purified antibody in PBS with 0.05% sodium azide and 50% glycerol. |
Application |
|
|---|---|
| WB | 1/500-1/2000 |
| IHC | 1/50-1/200 |
| ELISA | 1/2000-1/5000 |
Product Image
- Gel: 8%SDS-PAGE, Lysate: 40 μg, Lane 1-2: Human prostate tissue and testis tissue lysates, Primary antibody: P00152(ANGPT1 Antibody) at dilution 1/450, Secondary antibody: Goat anti rabbit IgG at 1/8000 dilution, Exposure time: 40 seconds
- The image is immunohistochemistry of paraffin-embedded Human thyroid cancer tissue using P00152(ANGPT1 Antibody) at dilution 1/50. (Original magnification: ×200)
- The image is immunohistochemistry of paraffin-embedded Human colon cancer tissue using P00152(ANGPT1 Antibody) at dilution 1/50. (Original magnification: ×200)
For Reseach Only
Application Key:WB - Western Blot | IHC - Immunohistochemistry | ICC - Immunocytochemistry | FCM - Flow Cytometry | ELISA - Enzyme-linked Immunosorbent Assay | IP - Immunoprecipitation
#P00152

相关产品















 微信/QQ登录
微信/QQ登录


 首页
首页